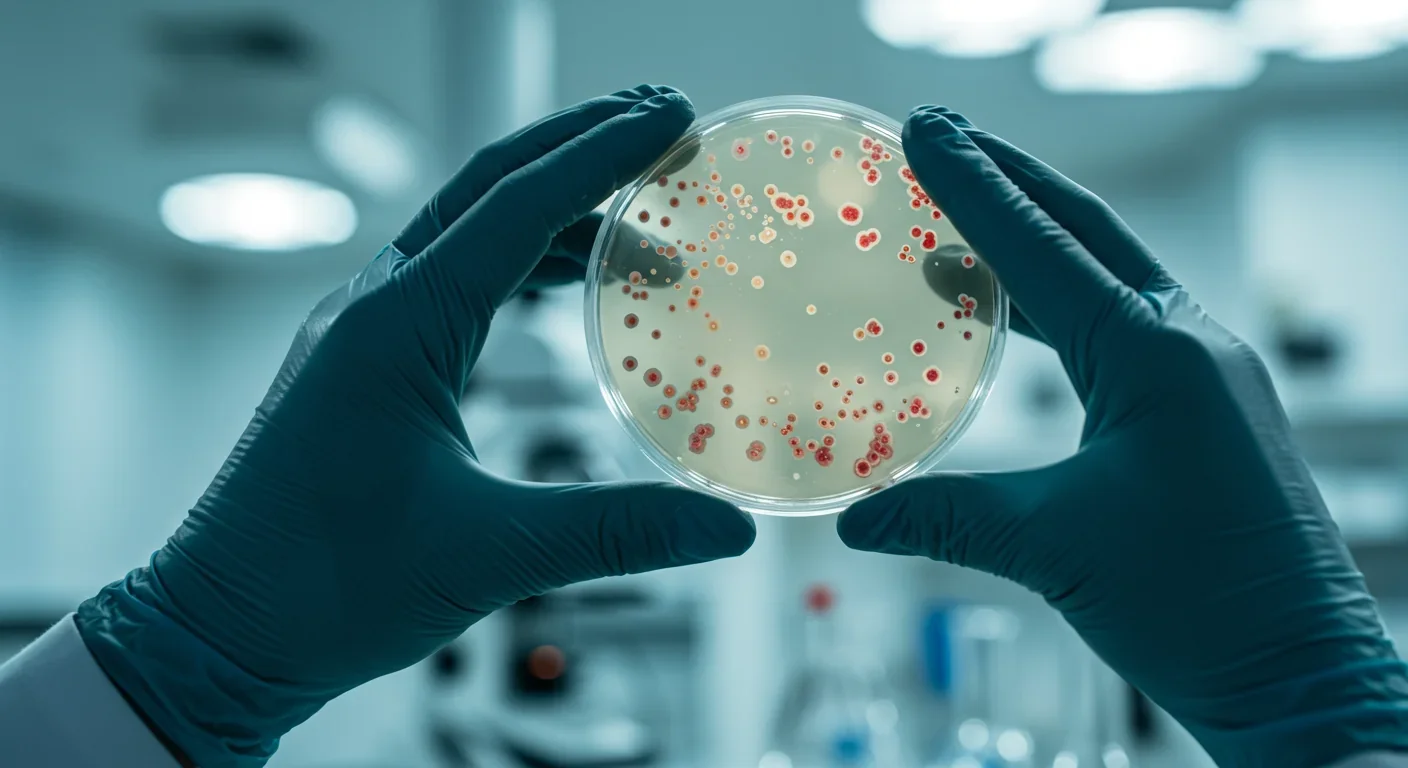

Epigenetic Clocks Predict Disease 30 Years Early

TL;DR: Gut bacteria are revolutionizing disease treatment by influencing everything from depression to autoimmune disorders through the gut-brain axis. Clinical trials show microbiome interventions can match pharmaceutical effectiveness, and simple dietary changes like eating more fiber and fermented foods can dramatically improve health outcomes.
Within the next decade, you'll likely visit a doctor who prescribes not just pills, but precise combinations of bacteria tailored to your unique gut ecosystem. The age of microbiome medicine has arrived, and it's rewriting the rules faster than most of us realize. Scientists have discovered that the trillions of microorganisms living in your intestines aren't just digesting food—they're orchestrating complex biochemical conversations with your brain, immune system, and nearly every organ in your body.
For decades, we treated the gut and brain as separate kingdoms. That worldview shattered when researchers started transplanting fecal matter from patients with major depressive disorder into germ-free mice. The results were startling: the mice developed depression-like behaviors, essentially "catching" depression from gut bacteria alone. This wasn't correlation anymore. It was causation.
The mechanism turns out to be inflammation. When your gut microbiome falls out of balance—a condition called dysbiosis—harmful bacteria can breach your intestinal barrier. This triggers a cascade: bacterial toxins called lipopolysaccharides leak into your bloodstream, activating immune cells that travel to your brain and spark neuroinflammation in regions like the hippocampus, which regulates mood and memory.
But here's where it gets interesting. The same dysbiosis driving depression also fuels autoimmune disorders. Your gut microbiome trains your immune system from birth, teaching it to distinguish friend from foe. When that training goes wrong, you get conditions like Crohn's disease, rheumatoid arthritis, and multiple sclerosis. The common thread? Microbial imbalance creating systemic chaos.
The clinical trial results are no longer theoretical. In one randomized controlled trial, a single fecal microbiota transplant improved metabolic markers in obese teenagers, addressing insulin resistance that conventional treatments had failed to touch. The mechanism? Changing gut bacteria composition altered how these teens' bodies processed energy at a fundamental level.
For inflammatory bowel disease, the data is even more compelling. A high-potency probiotic cocktail called VSL#3—containing multiple strains of Lactobacilli, Bifidobacteria, and Streptococci—prevents pouchitis recurrence after antibiotic treatment with remarkable consistency. This isn't alternative medicine. It's evidence-based immunotherapy leveraging the body's microbial ecosystem.
Mental health trials are showing similar promise. Researchers found that dietary modifications improving gut microbial composition led to measurable improvements in depression and anxiety, with effect sizes comparable to some pharmaceutical interventions. The key player? Short-chain fatty acids like butyrate, produced when beneficial bacteria ferment dietary fiber.
Butyrate deserves special attention because it reveals how elegantly the microbiome influences our health. This molecule, produced by bacteria like Faecalibacterium prausnitzii when they digest fiber, doesn't just nourish your gut lining. It crosses the blood-brain barrier and acts as a histone deacetylase inhibitor, literally switching genes on and off in your neurons to protect against neurodegeneration.
In one controlled study, butyrate supplementation reduced colonic inflammation markers by 35% in mice with inflammatory bowel disease. The same molecule also appears to calm overactive immune responses in autoimmune conditions by regulating T-cell populations. One metabolite, multiple therapeutic effects across seemingly unrelated diseases.
This explains why fermented foods are emerging as powerful therapeutic tools. Korean kimchi, Japanese natto, European sauerkraut—these traditional foods cultivate diverse bacterial communities that produce beneficial metabolites your body can't make on its own.
Artificial intelligence is compressing research timelines in remarkable ways. MIT researchers used an AI tool called DiffDock to map how a new antibiotic targets specific gut bacteria, completing in six months what would traditionally take 18-24 months. This matters because it opens possibilities for precision antibiotics that eliminate harmful bacteria while preserving beneficial species.
The National Natural Science Foundation of China has invested heavily in gut-microbiota research, funding over 20% of recent publications on insulin resistance and gut health. We're seeing similar commitments worldwide because the economic implications are staggering. If microbiome interventions can address even a fraction of autoimmune, metabolic, and psychiatric disorders, we're talking about hundreds of billions in reduced healthcare costs.
Not all gut bacteria are created equal. Akkermansia muciniphila has emerged as a superstar, with studies linking higher levels to protection against obesity, diabetes, and neurological decline. This mucus-dwelling bacterium strengthens your intestinal barrier and produces metabolites that dampen inflammation throughout your body.
On the flip side, Roseburia intestinalis shows reduced function in Parkinson's disease patients, producing less of the amino acid L-leucine that neurons need. Meanwhile, certain methane-producing bacteria appear to worsen neurodegeneration by consuming beneficial compounds before they can reach the brain.
The bacteria-brain connection runs through multiple highways. The vagus nerve provides a direct communication line, with electrical signals traveling from gut to brain in real-time. Bacterial metabolites enter the bloodstream and cross into neural tissue. Immune cells primed in the gut migrate to the brain, carrying inflammatory or anti-inflammatory signals depending on what microbes taught them.

The science is clear on actionable interventions. First, fiber intake matters more than almost anything else. Aim for 30-40 grams daily from diverse plant sources because different bacteria specialize in different fibers. Variety feeds diversity, and diversity equals resilience.
Second, incorporate fermented foods daily. A Stanford study found that just 6-10 weeks of regular fermented food consumption significantly increased microbiome diversity and reduced inflammatory markers. You don't need exotic probiotics—yogurt, kefir, sauerkraut, and kimchi all deliver living bacteria that can colonize your gut.
Third, minimize unnecessary antibiotic use. While sometimes essential, broad-spectrum antibiotics are like carpet-bombing your microbiome. If you must take them, consider following up with targeted probiotics to accelerate recovery of beneficial species.
Fourth, polyphenol-rich foods matter. Compounds in berries, green tea, dark chocolate, and nuts feed beneficial bacteria while inhibiting pathogens. These aren't supplements—they're ordinary foods that create extraordinary shifts in microbial populations when consumed regularly.
Before you rush out for every probiotic supplement on the shelf, understand the limitations. Most commercial probiotics contain transient species that pass through your system without colonizing. They may provide temporary benefits, but permanent shifts require either drastic interventions like fecal transplants or sustained dietary changes that create environments where beneficial bacteria thrive.
Fecal microbiota transplants, while promising, carry risks. There have been cases of pathogen transmission and unexpected weight gain when recipients received microbiomes from overweight donors. The FDA currently restricts FMT primarily to recurrent C. difficile infections while researchers work out safety protocols for broader applications.
We also don't fully understand individual variation. What works for one person's microbiome may fail for another because we each harbor unique bacterial communities shaped by genetics, early-life exposures, and decades of dietary patterns. Personalized microbiome testing is advancing, but we're not yet at the point where a simple test can prescribe exactly which foods or probiotics you need.
The implications for autoimmune disease are particularly profound. Traditional treatments suppress your entire immune system, leaving you vulnerable to infections and cancers. Microbiome-based interventions offer a different approach: retraining immune cells at their source rather than bluntly shutting them down.
Some bacteria produce metabolites that promote regulatory T cells—the immune system's peacekeepers that prevent attacks on your own tissues. Others influence gut barrier integrity, reducing the leakage of inflammatory compounds that can trigger autoimmune flares. By modulating these microbial populations, we might address root causes instead of just managing symptoms.
Research is exploring combinations of microbiome therapy with cutting-edge treatments like CAR T-cell therapy and bispecific antibodies. The idea is that a healthier microbiome might enhance these therapies' effectiveness while reducing side effects, creating synergistic benefits neither approach achieves alone.
How close are we to doctors routinely prescribing microbiome therapies? Closer than you might think, but with caveats. For inflammatory bowel disease, several microbiome-based treatments are already in late-stage clinical trials or regulatory review. The science is solid enough that specialized clinics are incorporating microbiome testing into treatment planning for IBD patients.
For mental health and metabolic disorders, we're maybe 5-10 years from widespread adoption. The mechanisms are well-established, but we need larger trials to determine optimal formulations, dosing, and patient selection criteria. Insurance coverage will lag behind the science, as it always does.
The regulatory landscape is evolving. Unlike traditional drugs that target single molecular pathways, microbiome therapies work through complex ecological interactions. The FDA is developing new frameworks to evaluate live biotherapeutic products, balancing innovation with safety concerns about introducing living organisms into patients.

The microbiome revolution extends beyond treating sick individuals. Some researchers are exploring whether early-life microbiome interventions could prevent diseases from developing. Infants born via C-section miss exposure to maternal vaginal bacteria, which may increase autoimmune and allergic disease risk later. Simple interventions like vaginal seeding—transferring maternal bacteria to newborns—are being tested to see if they can close this gap.
There's also fascinating work on psychobiotics—bacteria specifically selected to influence mental health through gut-brain pathways. While most research has focused on treating existing conditions, some scientists wonder whether optimizing microbiomes could enhance cognitive function and emotional resilience in healthy people. We're treading into murky ethical territory here, but the biological potential is undeniable.
Step back and consider what this means. We've spent the antibiotic era treating bacteria as enemies to be eliminated. Now we're realizing that our health depends on cultivating complex microbial ecosystems. This isn't just a medical shift—it's philosophical. We are not autonomous individuals but rather superorganisms whose wellbeing emerges from trillions of microscopic partnerships.
This reframing changes how we think about disease. Depression might not be purely a brain chemistry problem but a whole-body inflammatory state originating in the gut. Autoimmune disorders might stem from ecological collapse in intestinal communities rather than mysterious immune system defects. These aren't just semantics—they point toward fundamentally different treatment strategies.
The implications ripple outward to public health. If processed foods and chronic antibiotic use are degrading population-level microbiome health, we're seeing the downstream effects in rising rates of autoimmune, metabolic, and psychiatric disorders. Addressing this requires systemic changes to food systems, antibiotic stewardship, and even urban design that exposes children to diverse environmental microbes.
The next frontier is precision. Right now, most microbiome interventions are broad-spectrum: eat more fiber, consume fermented foods, maybe try a multi-strain probiotic. Within a decade, we'll likely have therapies as personalized as chemotherapy regimens, with specific bacterial strains selected based on your unique microbial profile, genetic markers, and health conditions.
We're also seeing completely unexpected applications. The "legalome"—using microbiome biomarkers in forensics and legal contexts. Microbiome signatures for early disease detection before symptoms appear. Even exploring whether gut bacteria influence decision-making and personality traits in ways that could inform psychiatry and neuroscience.
The science is moving fast enough that what sounds like science fiction today may be standard practice tomorrow. The tools exist. The mechanisms are increasingly clear. What remains is translating this knowledge into therapies that reach the millions of people suffering from conditions we can now understand—and potentially treat—through the lens of the microbiome.
Your gut bacteria have been working on your behalf since birth, teaching your immune system, producing vitamins, protecting against pathogens, and communicating with your brain through molecular languages we're only beginning to decode. The revolution isn't coming. It's already here, happening in research labs, clinical trials, and increasingly, in doctors' offices where the future of medicine is being written one microbe at a time.

Recent breakthroughs in fusion technology—including 351,000-gauss magnetic fields, AI-driven plasma diagnostics, and net energy gain at the National Ignition Facility—are transforming fusion propulsion from science fiction to engineering frontier. Scientists now have a realistic pathway to accelerate spacecraft to 10% of light speed, enabling a 43-year journey to Alpha Centauri. While challenges remain in miniaturization, neutron management, and sustained operation, the physics barriers have ...

Epigenetic clocks measure DNA methylation patterns to calculate biological age, which predicts disease risk up to 30 years before symptoms appear. Landmark studies show that accelerated epigenetic aging forecasts cardiovascular disease, diabetes, and neurodegeneration with remarkable accuracy. Lifestyle interventions—Mediterranean diet, structured exercise, quality sleep, stress management—can measurably reverse biological aging, reducing epigenetic age by 1-2 years within months. Commercial ...

Data centers consumed 415 terawatt-hours of electricity in 2024 and will nearly double that by 2030, driven by AI's insatiable energy appetite. Despite tech giants' renewable pledges, actual emissions are up to 662% higher than reported due to accounting loopholes. A digital pollution tax—similar to Europe's carbon border tariff—could finally force the industry to invest in efficiency technologies like liquid cooling, waste heat recovery, and time-matched renewable power, transforming volunta...

Humans are hardwired to see invisible agents—gods, ghosts, conspiracies—thanks to the Hyperactive Agency Detection Device (HADD), an evolutionary survival mechanism that favored false alarms over fatal misses. This cognitive bias, rooted in brain regions like the temporoparietal junction and medial prefrontal cortex, generates religious beliefs, animistic worldviews, and conspiracy theories across all cultures. Understanding HADD doesn't eliminate belief, but it helps us recognize when our pa...

The bombardier beetle has perfected a chemical defense system that human engineers are still trying to replicate: a two-chamber micro-combustion engine that mixes hydroquinone and hydrogen peroxide to create explosive 100°C sprays at up to 500 pulses per second, aimed with 270-degree precision. This tiny insect's biochemical marvel is inspiring revolutionary technologies in aerospace propulsion, pharmaceutical delivery, and fire suppression. By 2030, beetle-inspired systems could position sat...

The U.S. faces a catastrophic care worker shortage driven by poverty-level wages, overwhelming burnout, and systemic undervaluation. With 99% of nursing homes hiring and 9.7 million openings projected by 2034, the crisis threatens patient safety, family stability, and economic productivity. Evidence-based solutions—wage reforms, streamlined training, technology integration, and policy enforcement—exist and work, but require sustained political will and cultural recognition that caregiving is ...

Every major AI model was trained on copyrighted text scraped without permission, triggering billion-dollar lawsuits and forcing a reckoning between innovation and creator rights. The future depends on finding balance between transformative AI development and fair compensation for the people whose work fuels it.